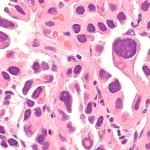
Lung cancer rise among nonsmokers prompts questions on screening

Jill Zarin’s Controversial Comments on Super Bowl Halftime Show
Jill Zarin, former Real Housewives of New York star, sparked controversy with her recent comments on the Super Bowl halftime show. Taking to her Instagram Story, Zarin didn’t hold back as she criticized the performances of Bad Bunny, Lady Gaga, and Ricky Martin.
Despite the potential backlash, Zarin boldly stated, “I don’t care if I lose half my followers over this.” She then bid farewell to any fans who may disagree with her opinions.
When it came to Bad Bunny’s performance, Zarin didn’t mince words. “I think it’s terrible. I was hoping it would get better, but it didn’t,” she expressed. Her dissatisfaction with the Latin artist’s segment was evident.
Turning her attention to Lady Gaga, Zarin made a surprising observation. “I didn’t recognize her, so she must’ve had a facelift,” she remarked. The reality TV personality also noted that Lady Gaga didn’t perform her usual hits, which left her feeling underwhelmed.
As for Ricky Martin, Zarin didn’t hold back. She claimed not to recognize the singer and even accused him of wearing a “bad wig.” Her critiques of the performers were certainly controversial.
Zarin also shared her thoughts on the overall theme of the halftime show. She suggested that there may have been subliminal messaging related to ICE and immigration, which she found concerning. Despite her boyfriend, Gary Brody, praising Bad Bunny’s performance as “creative,” Zarin stood by her opinion that the show missed the mark.
While opinions on the Super Bowl halftime show vary, Jill Zarin’s outspoken commentary has certainly stirred up conversation. Whether fans agree or disagree with her views, it’s clear that Zarin isn’t afraid to speak her mind.